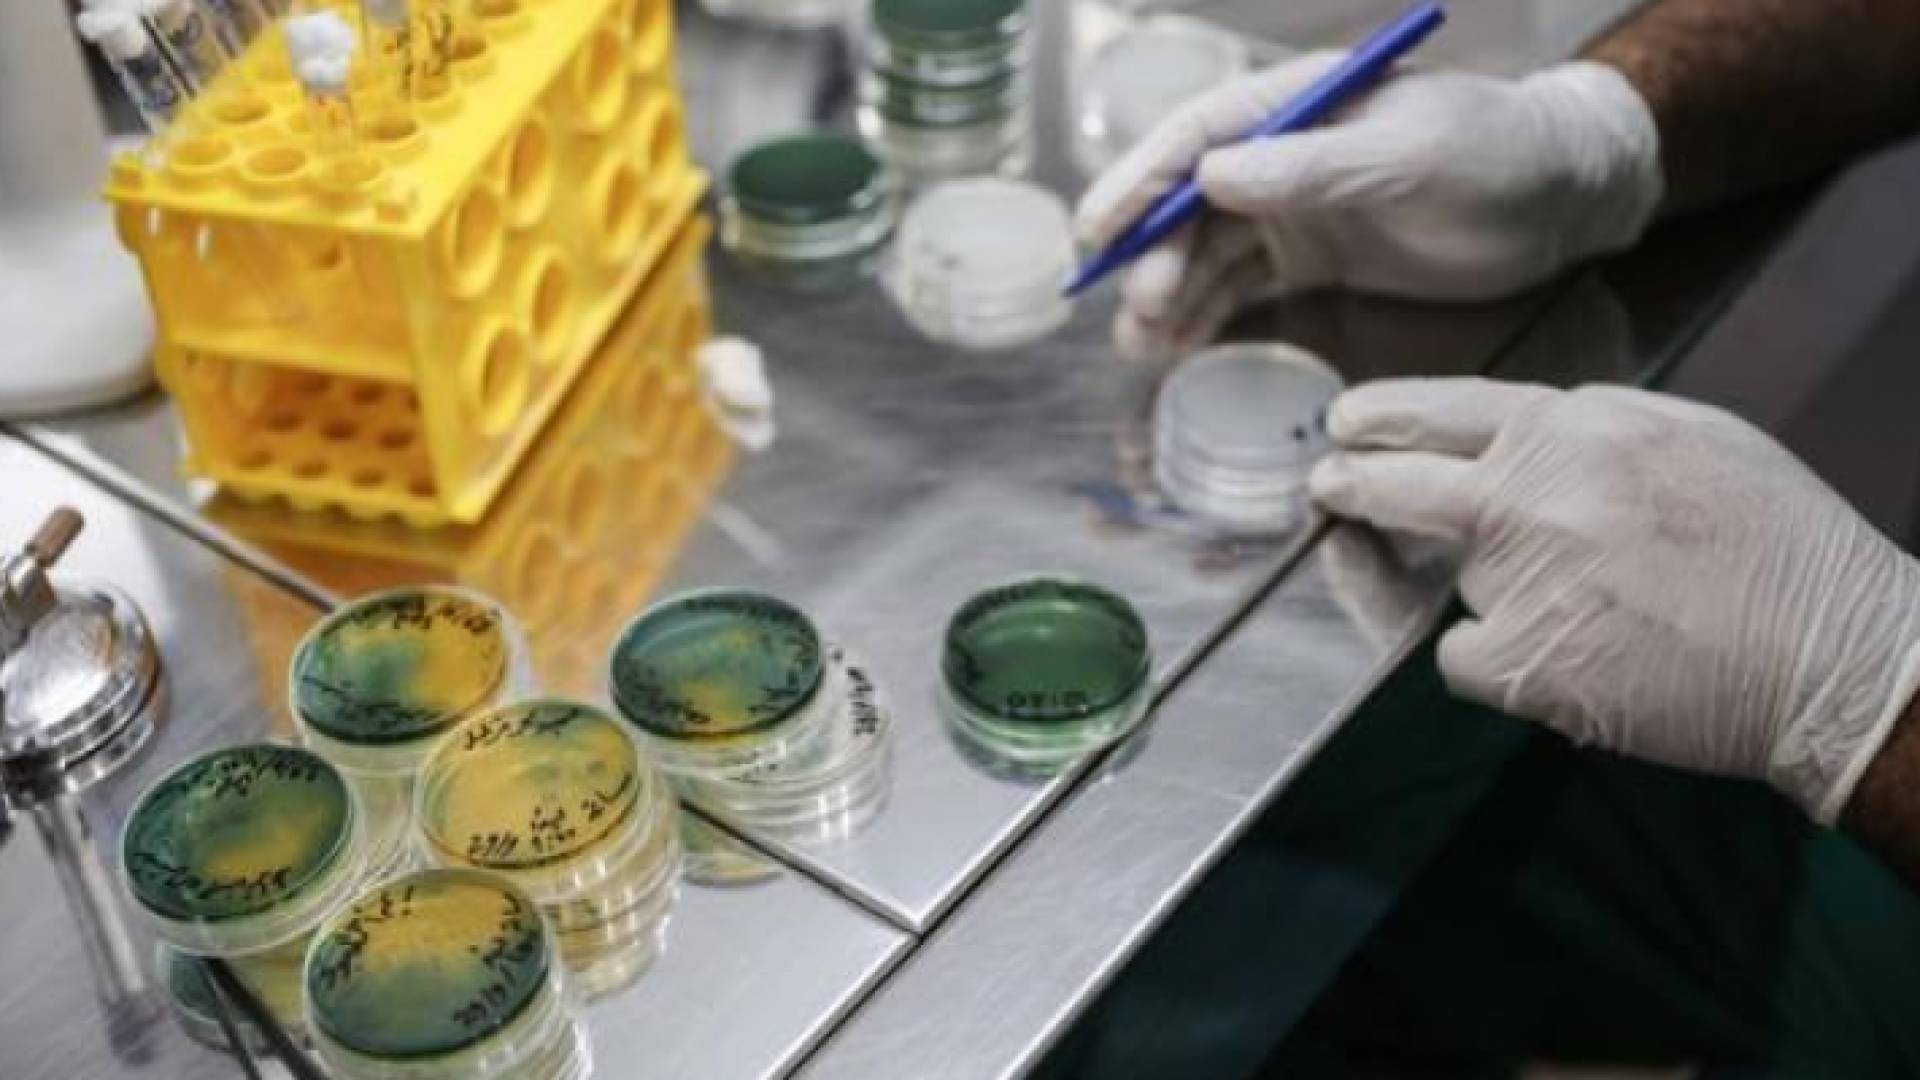
فحوص خاصة بمرض الكوليرا

فحوص خاصة بمرض الكوليرا
الحكومة تعلن موعد وصول فحوص الكوليرا
نشر :
12:20 2022-10-13|- مستشار رئاسة الوزراء لشؤون الصحة: الأردن خال من الكوليرا
- البلبيسي: فحوصات الكوليرا تظهر النتيجة في 15 دقيقة
أعلن مستشار رئاسة الوزراء لشؤون الصحة الدكتور عادل البلبيسي، عن وصول 2500 فحص سريع لمرض الكوليرا مطلع الأسبوع المقبل إلى الأردن.
وقال البلبيسي في تصريحات للتلفزيون الأردني، إن الفحص يظهر النتيجة خلال 15 دقيقة، مضيفا أنها ستوزع في مختلف مناطق المملكة، خصوصا محافظات الشمال لقربها من الحدود السورية.
مطاعيم الكوليرا
وبخصوص المطاعيم، أوضح أن فعاليتها قليلة وتستخدم في المناطق التي ينتشر فيها المرض والمناطق المحصورة كمخيمات اللاجئين.
وأكد البلبيسي أن المملكة خالية من الكوليرا، مشيرا إلى أن الأردن يعمد على إجراء الفحوصات الدورية للمواطنين في هذا الخصوص.